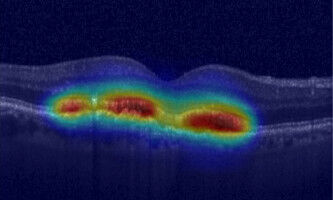
KI könnte bald Ihre Augenarzt-Termine mitbestimmen

news
Universität Bern
Ergebnisse 181 - 200 von 619.
Geowissenschaften - Umwelt - 30.06.2021

Ein internationales Forschungsteam mit Berner Beteiligung zeigt, dass der Ausbruch des Laacher See Vulkans und damit auch der letzte grosse Temperatursturz am Ende der letzten Eiszeit (die Jüngere Dryas) 126 Jahre früher stattfanden als bisher angenommen. Dieses Resultat soll nun helfen, die globalen Klimafolgen des Ausbruchs genauer zu rekonstruieren sowie die Ursachen für den Kälterückfall der Jüngeren Dryas zu entschlüsseln.
Astronomie & Weltraum - Physik - 28.06.2021

Bei der Untersuchung von zwei Exoplaneten in einem hellen, nahe gelegenen Sternsystem hat der CHEOPS-Satellit den dritten bekannten Planeten des Systems ausgemacht, der unerwarteterweise die Oberfläche des Sterns kreuzte. Dieser Transit offenbart spannende Details über einen «beispiellosen Planeten», wie das wissenschaftliche Team unter der Leitung der Universitäten Genf und Bern sowie Mitglieder des Nationalen Forschungsschwerpunkts PlanetS betonen.
Umwelt - 25.06.2021

Im Vergleich zu anderen Regionen der Schweiz wie Jura und Nordalpen weist die Luchspopulation in den südwestlichen Schweizer Alpen eine unerwartet niedrige Dichte auf. Um dies zu erklären, haben Forschende unter der Federführung von Raphaël Arlettaz vom Institut für Ökologie und Evolution der Universität Bern vier Hypothesen getestet.
Astronomie & Weltraum - Biowissenschaften - 18.06.2021

Es könnte ein Meilenstein auf dem Weg zum Nachweis von Leben auf anderen Planeten sein: Forschenden unter der Leitung des Nationalen Forschungsschwerpunkts (NFS) PlanetS, den die Universität Bern gemeinsam mit der Universität Genf leitet, ist es gelungen, mehrere Kilometer über dem Boden aus einem Hubschrauber eine zentrale molekulare Eigenschaft aller Lebewesen zu messen.
Gesundheit - 08.06.2021
Drei der häufigsten chronischen Augenerkrankungen erfordern regelmässige Kontrolluntersuchungen und Injektionen ins Auge, um eine drohende Erblindung abzuwenden. Eine Studie der Universität Bern und des Inselspitals, Universitätsspital Bern in Zusammenarbeit mit einem Startup für Anwendungen künstlicher Intelligenz (KI) in der Augenheilkunde zeigt nun, dass sich die ideale individuelle Untersuchungshäufigkeit von Patientinnen und Patienten recht genau durch maschinelles Lernen vorhersagen lässt - mit einem dreifachen Nutzen.
Umwelt - 02.06.2021

Eine am Oeschger-Zentrum für Klimaforschung der Universität Bern entstandene Studie liefert neue Erkenntnisse zur Verschmutzung der Weltmeere mit Plastikmüll. Die Modellierungen zeigen, dass der grösste Teil des Plastiks nicht auf den offenen Ozean gelangt, sondern strandet oder küstennah im Wasser treibt.
Gesundheit - Umwelt - 31.05.2021

Eine internationale Studie, koordiniert von der Universität Bern und der London School of Hygiene & Tropical Medicine, zeigt erstmals den tatsächlichen Beitrag des menschengemachten Klimawandels an hitzebedingten Todesfällen. Zwischen 1991 und 2018 waren mehr als ein Drittel aller Todesfälle, bei denen Hitze eine Rolle spielte, auf die Klimaerwärmung zurückzuführen.
Karriere - Psychologie - 05.05.2021
Beruflicher Erfolg beeinflusst die Persönlichkeit
Eine Studie ergibt, dass beruflicher Erfolg grundlegende Persönlichkeitseigenschaften verändern kann: Stiegen im Verlauf von acht Jahren das berufliche Prestige und Einkommen an, ging dies mit zunehmender emotionaler Stabilität und Offenheit für Erfahrungen sowie abnehmender Extraversion einher. Persönlichkeitseigenschaften wurden in der wissenschaftlichen Psychologie lange Zeit als stabil angenommen.
Umwelt - 04.05.2021

Forschende der Universität Bern haben eine neue verhaltensökonomische Methode entwickelt, um die Wirkung von CO2-Preisen und ihrer Folgen für die Umwelt unter kontrollierten Laborbedingungen zu testen: der Carbon Emission Task . Die Ergebnisse ermöglichen eine Erforschung der Wirksamkeit von CO2-Steuern, die in der Bekämpfung des Klimawandels als zentrales Lenkungsinstrument gelten.
Umwelt - 28.04.2021

Die Weltmeere sind ein wichtiger CO2-Speicher. Doch wieviel Kohlendioxid können sie künftig tatsächlich aufnehmen? Entsprechende Prognosen wiesen bisher eine grosse Bandbreite auf. Berner Klimaforschende konnten nun die Leistung des Südpolarmeers als sogenannte CO2-Senke genauer bestimmen. Wer den globalen Kohlenstoffkreislauf erforscht, hat es mit unvorstellbar grossen Zahlen zu tun.
Umwelt - 14.04.2021

Erstmals haben Forschende des Oeschger-Zentrums für Klimaforschung der Universität Bern mithilfe von antarktischen Eiskerndaten die globale mittlere Ozeantemperatur für ausgewählte Zeitabschnitte der letzten 700'000 Jahre rekonstruiert. Die so gewonnen Erkenntnisse dienen dem besseren Verständnis des Klimasystems.
Geowissenschaften - Umwelt - 14.04.2021

Lange konnten sich Klimaforschende die hohe Konzentration an Treibhausgasen in der Erdatmosphäre vor rund drei Milliarden Jahren nicht erklären. Nun hat ein internationales Forschungsteam mit Beteiligung von Hendrik Vogel vom Institut für Geologie und vom Oeschger-Zentrum für Klimaforschung der Universität Bern das Rätsel gelöst. Sedimentanalysen ergaben die überraschende Erkenntnis, dass Mikroben unter den damaligen Bedingungen beim Stoffwechsel hauptsächlich das hochwirksame Treibhausgas Methan produzierten.
Biowissenschaften - Informatik - 14.04.2021

Ein internationales Forschungsteam rekonstruierte anhand von Genomsequenzierungen die menschliche Besiedlungsgeschichte im Südpazifik. Beteiligt an der Studie war auch Laurent Excoffier, Professor am Institut für Ökologie und Evolution der Universität Bern und Gruppenleiter am SIB Schweizerisches Institut für Bioinformatik.
Gesundheit - Sozialwissenschaften - 08.04.2021
Jedes vierte Kind wünscht bessere Schmerzbehandlung
In einer grossen Studie haben das Inselspital, Universitätsspital Bern und die Universität Bern in zwölf Zentren und vier europäischen Ländern Untersuchungen zur Schmerzbehandlung während einer Operation bei Kindern durchgeführt. Die Analyse der Daten ergab bei fast jedem vierten Kind Optimierungsbedarf.
Physik - 07.04.2021

Das US-amerikanische Forschungslabor 'Fermilab' hat die mit Spannung erwarteten Ergebnisse der experimentellen Messung des sogenannten anomalen magnetischen Dipolmoments des Myons veröffentlicht. Als Mitglieder der 'Muon g-2 Theory Initiative' haben Forschende der Universität Bern parallel dazu dieselbe physikalische Grösse basierend auf dem Standardmodell theoretisch berechnet.
Gesundheit - Biowissenschaften - 17.03.2021

Forschende der Universität Bern konnten zeigen, dass die Beseitigung einer Barriere im Fluss dazu führt, dass einheimische Bachforellen wieder in Laichgewässer aufsteigen, und dabei nicht zur Ausbreitung der gefürchteten Fisch-Erkrankung PKD beitragen. Die Ergebnisse bekräftigen, dass die Durchgängigkeit von einheimischen Gewässern wichtig ist, um bedrohte Fischarten und somit auch die Biodiversität zu erhalten.
Geowissenschaften - Umwelt - 12.03.2021

Obwohl vergangene Temperaturschwankungen in den Tropen für das Verständnis des globalen Klimasystems von grosser Bedeutung sind, ist über ihr Ausmass und den zeitlichen Verlauf noch wenig bekannt. Forschende unter der Leitung der Universität Bern konnten nun anhand von Gletscherschwankungen und riesigen Steinstreifen im Äthiopischen Hochland eine starke lokale Abkühlung in den Tropen während der letzten Kaltzeit nachweisen.
Astronomie & Weltraum - Umwelt - 11.03.2021

Die Verwitterung von Silikatgesteinen trägt massgeblich dazu bei, dass auf der Erde ein gemässigtes Klima herrscht. Forschende unter der Leitung der Universität Bern und des nationalen Forschungsschwerpunkts (NFS) PlanetS, untersuchten die allgemeinen Prinzipien dieses Prozesses. Ihre Ergebnisse könnten beeinflussen, wie wir die Signale von fernen Welten interpretieren - auch solche, die auf Leben hindeuten könnten.
Gesundheit - Pharmakologie - 08.03.2021

Aus von Prostata-Tumoren entnommenen Biopsien haben Forschende der Universität Bern und des Inselspitals, Universitätsspital Bern sogenannte Organoide gezüchtet. An diesen kleinen Zellhaufen lässt sich die Wirksamkeit verschiedener Medikamente testen. So kann vor Therapiebeginn ermittelt werden, von welcher Behandlung die Betroffenen am ehesten profitieren.
Gesundheit - Pharmakologie - 05.03.2021

Verwachsungen im Bauchraum, die etwa nach Operationen entstehen, haben oft schwerwiegende Folgen. Nun haben Forschende der Universität Bern und des Inselspitals, Universitätsspital Bern, in Zusammenarbeit mit kanadischen Forschenden entdeckt, wie sich solche Verwachsungen bilden. Die Erkenntnisse können dazu beitragen, ein Medikament zu entwickeln, um künftig Verwachsungen verhindern zu können.













